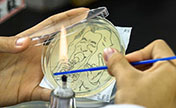
???? ?????? ?????? ??????????

??????? 2 ?????? 2018 / ??? ???? ???????? ???????? ?? ???? ?? ??? ????? ????? ??? ????? ??????? ??????.
??? ???? ??? ???? ?????? ??????? ?????? ?????? ????? ????? ??????? ???? ????????? ???? ???? ????? ?????? ????? ???? ?? ?????? ?????? ????? ??? ????? ????? ????? ??? ?????.
???? ?? ???? ?????? ??????? ?? ???? ????? ???? ????? ??? ??????? ?????? ???????? ???????? ?????? ??? "?? ??????? ????? ???? ?????? ????????? ?????? ?????? ???????? ???? ????? ????? ????." ????? ?????? ????? ??????? ????? ?????? ????? ???????? ??????? ?????.
????? ?? ?? 10 ???? ?? ????? ???? ????? ??? ??????? ?????? ??? ?????? ?? ????? ???????. ????? ????????? ??? ???? ????? ?????? ?????? ??????? ????? ??????? ??????.
???? ?? "??? ??????? ??????? ??????? ?????? ????? ????????? ????????? ?? ???? ????? ??????? ?????? ??? ???? ???? ?????????.
???? ?? ???? ?????? ????? ??????? ?????? ????? ????? ??????? ?????.
 |
 40 ??? ?? ??????? ?????????: ????? ?? ???? ????? ??? ???? ??????? ?????
40 ??? ?? ??????? ?????????: ????? ?? ???? ????? ??? ???? ??????? ????? ??? ?????: ???? ?????? ??????
??? ?????: ???? ?????? ?????? ???? " ??? ??? ??????? ?????????" ???? ????? ???????? ??? ??????? ???????
???? " ??? ??? ??????? ?????????" ???? ????? ???????? ??? ??????? ??????? ???? ???? ???? ?????? ????? ???? 20 ????
???? ???? ???? ?????? ????? ???? 20 ???? ??????: ???? ???? ?????? ?? ?????
??????: ???? ???? ?????? ?? ????? ????? ???? ???????? ?????? ??????? ?????? ?? ??????
????? ???? ???????? ?????? ??????? ?????? ?? ?????? ????? ??????? ???? ?????? ?? 267 ????? ???? ???? ??????
????? ??????? ???? ?????? ?? 267 ????? ???? ???? ?????? "???? ??? ??????" ???? ????? ????? ??????? ?????? ??????
"???? ??? ??????" ???? ????? ????? ??????? ?????? ?????? ??? ????? ???? ???? .. ????? ?? ????? ????? ???? ??? ?????? ?????????
??? ????? ???? ???? .. ????? ?? ????? ????? ???? ??? ?????? ????????? "??????? ????????"? ????? ??????? ???????? ??????? ??????? ?? ??????? ???????
"??????? ????????"? ????? ??????? ???????? ??????? ??????? ?? ??????? ??????? "?????? ???????" ???? ????? ????? ?? ?????? ??????
"?????? ???????" ???? ????? ????? ?? ?????? ?????? ?? ???? ??? ????? ????? ????? ????????
?? ???? ??? ????? ????? ????? ???????? ???? ?????? ?????? ??????????
???? ?????? ?????? ?????????? ???? ?????? ?????? ??????? ????? ???? ??????? ?????????
???? ?????? ?????? ??????? ????? ???? ??????? ????????? ???? ?????? ???? ??????? ?????????
???? ?????? ???? ??????? ?????????